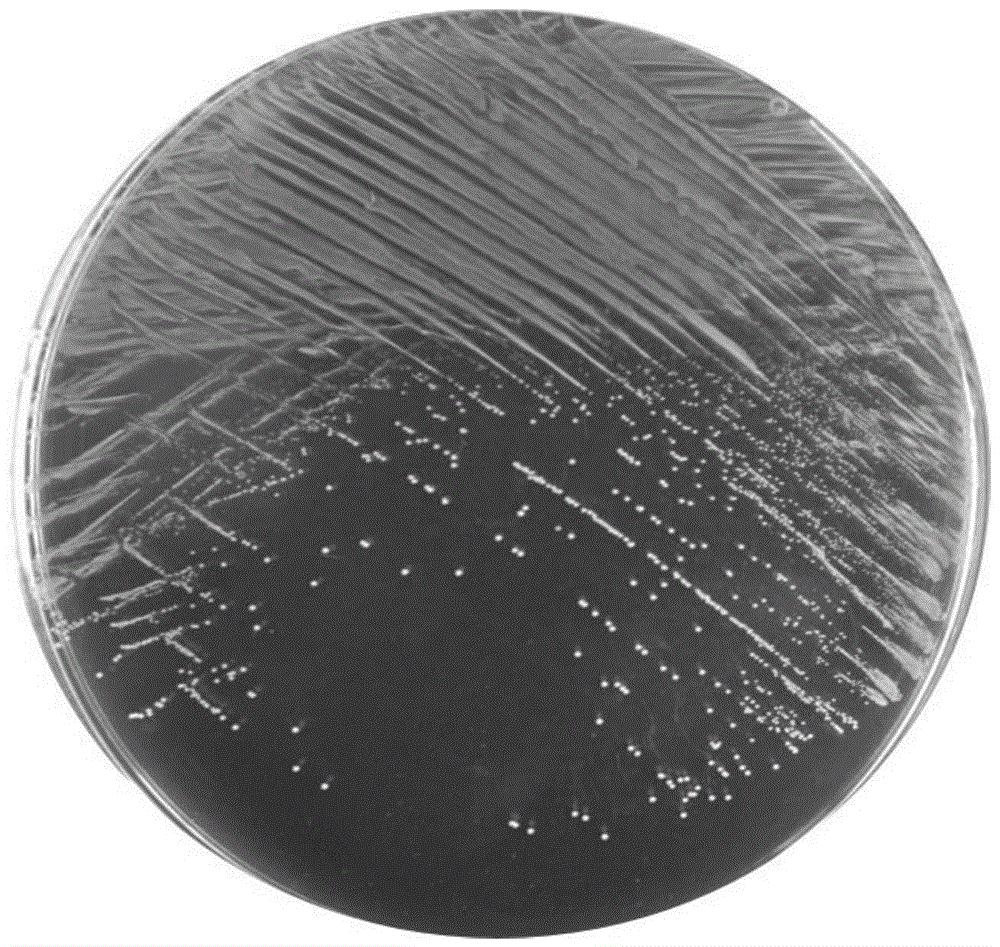
一种唾液乳杆菌y4及其应用
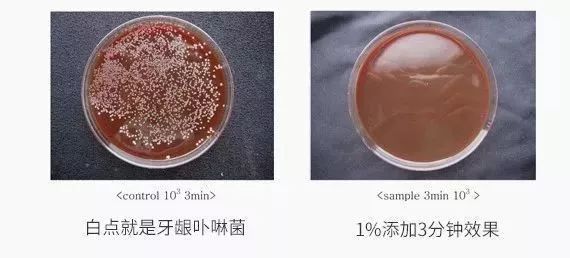
有相关机构做过实验,在唾液中添加乳香,10分钟后进行对比,可以很直观

唾液乳杆菌

唾液乳杆菌
图片尺寸1000x750
唾液乳杆菌
图片尺寸1200x899
唾液乳杆菌100亿cfu/g 活性益生菌 肠道乳杆菌 食品级 源头厂家
图片尺寸360x360
一种唾液乳杆菌y4及其应用的制作方法
图片尺寸1000x947
一株唾液乳杆菌及其用途的制作方法
图片尺寸1000x758
一种唾液乳杆菌y4及其应用
图片尺寸1000x947
有相关机构做过实验,在唾液中添加乳香,10分钟后进行对比,可以很直观
图片尺寸570x258
唾液乳杆菌ls01
图片尺寸1000x750
唾液乳杆菌li01的作用
图片尺寸775x455
抗过敏益生菌有什么?唾液乳杆菌
图片尺寸550x367
salivarius唾液乳酸菌15g24.
图片尺寸800x800
唾液乳杆菌 唾液乳酸菌 唾液益生菌冻干粉 盒装胶囊 有机浓缩
图片尺寸800x800
唾液乳杆菌ls01战胜特皮的幕后黑手
图片尺寸1242x1554
90罗伊氏乳杆菌gl-104:有效调节食物,皮肤,呼吸道过敏,提高免疫力
图片尺寸1080x1439
因此,卫之幽专利唾液乳酸菌分是幽门螺杆菌的天敌,根据填补stp2乳酸菌
图片尺寸500x321
《食品科学》:吉林农业大学任大勇副教授等:唾液乳杆菌膜外蛋白对金
图片尺寸629x424
软糖添加了三种益生菌(分别是植物乳杆菌,唾液乳杆菌和副干酪乳杆菌)
图片尺寸1080x1080
口腔细菌有多可怕?
图片尺寸640x531
口腔里细菌那么多,那接吻的时候细菌会通过唾液转移到另一个人的口腔
图片尺寸2976x3968
1000亿/克 唾液乳杆菌 食品级益生菌冻干粉原料 食用级乳酸菌粉
图片尺寸230x230